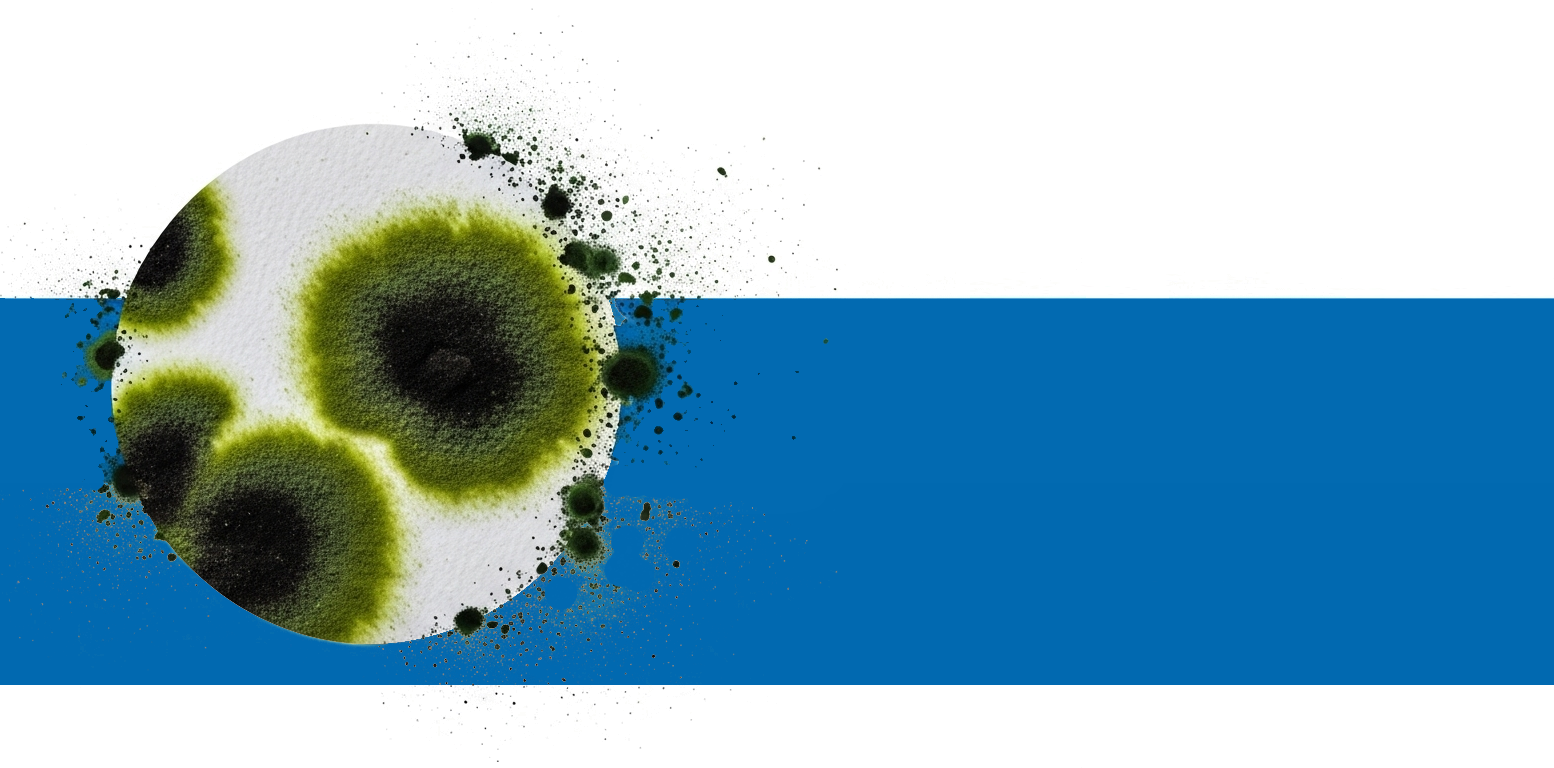

Mold Inspection & Testing Services
Professional mold assessments to protect your health and property
South Florida's humid climate creates the perfect conditions for mold growth, making professional mold inspection essential for protecting your family's health and your property investment. At Kenco Home Inspections, our Florida State Licensed Mold Assessors use advanced testing methods to identify hidden mold issues before they become serious problems. With over 23 years of experience in Southeast Florida, we understand the unique mold challenges that Palm Beach, Martin, St. Lucie, Broward, and Indian River County residents face.
Comprehensive Mold Assessment Services

Visual Mold Inspection
Thorough visual examination of your property to identify visible mold growth, moisture issues, and potential problem areas.

Air Quality Testing
Professional air sampling to detect airborne mold spores and assess indoor air quality levels throughout your property.


Surface Testing
Direct sampling of suspected mold growth areas to identify specific mold types and concentration levels.

Moisture Detection
Advanced moisture meters and thermal imaging to identify hidden moisture sources that promote mold growth.

Detailed Reporting
Comprehensive written reports with lab results, photographs, and recommendations for remediation if needed.

Expert Consultation
Professional guidance on interpretation of results and next steps for maintaining a healthy indoor environment.

Why Choose Kenco for Mold Inspection?
Licensed Mold Assessor on Staff
Florida State Licensed Mold Assessor ensures professional, compliant inspections.
State-of-the-Art Equipment
Latest testing technology and certified laboratory analysis for accurate results
Fast Turnaround
Same-day inspection with results typically available within 24-48 hours.
Independent & Unbiased
We don't perform remediation, ensuring objective assessments and recommendations.
Perfect for South Florida
Florida's humid climate creates ideal conditions for mold growth. Our local expertise helps identify and address mold issues specific to our region:
✓ High humidity environments
✓ Post-hurricane moisture damage
✓ HVAC system contamination
✓ Hidden water leaks
✓ Basement and crawl space issues

Protect Your Health and Property Today
Don't wait for visible mold growth. Early detection can save you thousands in remediation costs and protect your family's health.
Email: hello@kenco.org
Serving Palm Beach, Martin, St. Lucie, Indian River & Broward Countie

